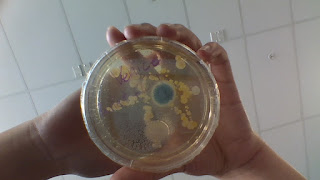

Hello everyone.
For wananga we had to do a writing prompt. One of the choices was a free choice which you can write your own story with your own topic. I chose to finish one of writing prompts I made near term 3.
Here is a link to the first part. Link
Here is the continue:
“Meet me tomorrow at the last stop? What does that mean?” I asked myself. I turned the piece of paper hoping to find more clues but only ended up having my hopes up for nothing. I snuck the piece of paper into my pockets. While reaching for my pockets I felt a string of some sort touch my fingertips. I pulled it out of my pockets and to my surprise it was a hair tie. I decided to tie my soft brunette hair, pushing it back to allow me to see my surroundings better.
I went back inside the bus sliding my fingers across the seats looking for another clue. As I turn my head left to right I start to see words engraved on the metal walls. I moved towards it trying to take a better look at what it said.
“Hello, can anyone see this?” It wrote.
“Yes.” it answered.
“What’s your favorite colour? Mine is green.” they wrote.
“I like green too but I prefer the colour brown, a light brown actually.” they answered by writing. Suddenly reading all these words I remember some of my memories that I lost before I had a coma.
I could recall the exact emotions I felt while reading the engraved writings on the wall. I was at a seat next to a window and below the window, writing from my pen-pal was engraved on it. I would always sit on that seat hoping my pen-pal had already replied to all my writings.
It was a seat found behind the 5 front rows of seats, barely in the middle of the bus. After a long day of school and barely surviving I found peace talking to this person. We met in person once or twice and shared contact numbers with each other so we actually trust each other.
After zoning out I find myself smiling as I touch the engraved words on the walls. I stopped and brushed off the feeling and memories I felt. I started to look around at the front window of the bus trying to focus on my initial goal.
I notice dents and light scratches on the hood of the bus. It’s surprising that they never thought to renovate the bus. I went outside to take a closer look at the hood of the bus. I saw traces of paint leaking underneath the bumper. I crouched down to see what it was. Words were written on it, though it was upside down from my view.“˙ ǝɹǝɥ ǝɹǝʍ ɹǝɥʇǝ∀ puɐ ǝǝlʎW”.
I laid down on the green thick grass to take a closer look. It said “ Mylee and Aether were here”. I thought for a second…….and then I realized, My name was also Mylee?! Though I wondered to myself “Who is Aether?” Another mystery was yet to be solved…..
Thank you for reading this blog post.